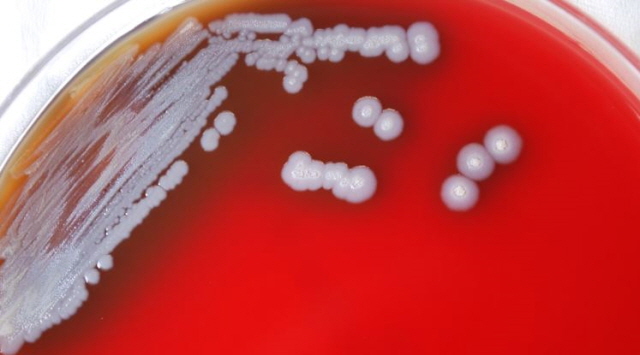
이미지

[해외토픽]
베트남에서 한 10대 여성이 세균성 감염병 '메리오이드증(Melioidosis)'에 걸려 한 달 만에 사망했다.
지난 19일(현지시간) VN익스프레스 등 외신에 따르면 베트남 중부 타인호아성에 살던 A양(15)은 지난달 말 유비저균(Burkholderia Pseudomallei)에 감염돼 발생하는 풍토병 메리오이드증에 걸렸다. 그는 인후통, 기침, 고열 등을 겪었으며 열흘 동안 7kg이 빠졌다. 약을 먹었지만 호흡 곤란, 저혈압, 청색증(혈액 속 산소 공급이 부족해 피부가 파랗게 변하는 상태) 등을 겪었다. 이후 타인호아어린이병원에서 정밀 검사를 했더니 '식인 박테리아'라고 불리는 유비저균에 감염된 것이 확인됐다. A양은 인공호흡기를 달고 투석 치료를 받았으나 지난 17일 사망했다. 베트남 보건당국에 따르면 A양은 당뇨와 비만을 앓았지만 피부에는 긁힌 상처가 없어 유비저균에 어떻게 노출됐는지 확실하지 않다.
메리오이드증은 유비저균에 의해 발병하는 세균성 감염병이다. 이 질환은 균 감염 부위에 따라 증상도 다를 수 있다. 폐에 감염되면 보통 잦은 기침과 호흡 곤란을 겪는다. 특정 피부가 감염되면 종기가 생길 수 있고, 림프절이 부을 수 있다. 만약 혈관에도 균이 침투하면 관절 통증이나 복통 등까지 동반된다. 또한 감염 부위와 상관없이 메리오이드증 환자들은 대부분 고열을 앓는다. 메리오이드증의 잠복기는 2~4주로 알려졌다.
이 질환은 오염된 토양, 물, 공기에 노출됐을 때 발병 위험이 커진다. 유비저균은 이런 오염된 환경에서 발견되는 박테리아다. 특히 상처로 인해 피부가 벌어졌거나 오염된 물을 마시게 되면 감염 확률이 높아진다. 그리고 당뇨나 만성 신장 질환 등을 앓고 있으면 발병하기 쉽다. 메리오이드증은 사람과 동물 모두가 걸릴 수 있지만, 사람 사이에 전염되는 것은 매우 드물며 동물이 사람을 감염시키지는 않는다.
현재 메리오이드증 환자들은 세프타지딤(Ceftazidime), 메로페넴(Meropenem) 등 여러 항생제를 사용해 치료를 받는다. 의료진은 먼저 2주 동안 정맥 주사를 주입한다. 그리고 최소 3개월간 약물을 복용하며 경과를 지켜본다. 이 질환은 광범위한 항생제로 치료하면 효과적이라고 알려졌다. 하지만 증상이 빠르게 퍼지거나 기저질환이 있다면 사망률도 빠르게 높아지기 때문에 신속히 치료받는 것이 좋다.
유비저균에 대한 백신은 아직 없기 때문에 일상생활에서 예방하는 것이 중요하다. 유비저균은 동남아시아나 호주 북부 지역에서 주로 발견된다. 따라서 해당 지역을 방문할 때는 오염된 물이나 흙 근처에 가지 않는 것이 좋다. 특히 피부에 상처가 났을 때 균에 감염되지 않도록 조심해야 한다. 만약 오염된 환경에 노출됐다면 바로 물로 해당 부위를 씻겨내고, 장갑이나 마스크를 착용한다. 필요할 경우 전문가에게 미리 항생제를 처방받는 것도 방법이다. 메리오이드증은 우리나라에서 지난 2013년에 첫 환자가 보고됐다. 미국 질병통제예방센터는 보고되지 않은 환자까지 포함해 매년 전 세계에 약 16만 건이 발생하는 것으로 예측한다.
지난 19일(현지시간) VN익스프레스 등 외신에 따르면 베트남 중부 타인호아성에 살던 A양(15)은 지난달 말 유비저균(Burkholderia Pseudomallei)에 감염돼 발생하는 풍토병 메리오이드증에 걸렸다. 그는 인후통, 기침, 고열 등을 겪었으며 열흘 동안 7kg이 빠졌다. 약을 먹었지만 호흡 곤란, 저혈압, 청색증(혈액 속 산소 공급이 부족해 피부가 파랗게 변하는 상태) 등을 겪었다. 이후 타인호아어린이병원에서 정밀 검사를 했더니 '식인 박테리아'라고 불리는 유비저균에 감염된 것이 확인됐다. A양은 인공호흡기를 달고 투석 치료를 받았으나 지난 17일 사망했다. 베트남 보건당국에 따르면 A양은 당뇨와 비만을 앓았지만 피부에는 긁힌 상처가 없어 유비저균에 어떻게 노출됐는지 확실하지 않다.
메리오이드증은 유비저균에 의해 발병하는 세균성 감염병이다. 이 질환은 균 감염 부위에 따라 증상도 다를 수 있다. 폐에 감염되면 보통 잦은 기침과 호흡 곤란을 겪는다. 특정 피부가 감염되면 종기가 생길 수 있고, 림프절이 부을 수 있다. 만약 혈관에도 균이 침투하면 관절 통증이나 복통 등까지 동반된다. 또한 감염 부위와 상관없이 메리오이드증 환자들은 대부분 고열을 앓는다. 메리오이드증의 잠복기는 2~4주로 알려졌다.
이 질환은 오염된 토양, 물, 공기에 노출됐을 때 발병 위험이 커진다. 유비저균은 이런 오염된 환경에서 발견되는 박테리아다. 특히 상처로 인해 피부가 벌어졌거나 오염된 물을 마시게 되면 감염 확률이 높아진다. 그리고 당뇨나 만성 신장 질환 등을 앓고 있으면 발병하기 쉽다. 메리오이드증은 사람과 동물 모두가 걸릴 수 있지만, 사람 사이에 전염되는 것은 매우 드물며 동물이 사람을 감염시키지는 않는다.
현재 메리오이드증 환자들은 세프타지딤(Ceftazidime), 메로페넴(Meropenem) 등 여러 항생제를 사용해 치료를 받는다. 의료진은 먼저 2주 동안 정맥 주사를 주입한다. 그리고 최소 3개월간 약물을 복용하며 경과를 지켜본다. 이 질환은 광범위한 항생제로 치료하면 효과적이라고 알려졌다. 하지만 증상이 빠르게 퍼지거나 기저질환이 있다면 사망률도 빠르게 높아지기 때문에 신속히 치료받는 것이 좋다.
유비저균에 대한 백신은 아직 없기 때문에 일상생활에서 예방하는 것이 중요하다. 유비저균은 동남아시아나 호주 북부 지역에서 주로 발견된다. 따라서 해당 지역을 방문할 때는 오염된 물이나 흙 근처에 가지 않는 것이 좋다. 특히 피부에 상처가 났을 때 균에 감염되지 않도록 조심해야 한다. 만약 오염된 환경에 노출됐다면 바로 물로 해당 부위를 씻겨내고, 장갑이나 마스크를 착용한다. 필요할 경우 전문가에게 미리 항생제를 처방받는 것도 방법이다. 메리오이드증은 우리나라에서 지난 2013년에 첫 환자가 보고됐다. 미국 질병통제예방센터는 보고되지 않은 환자까지 포함해 매년 전 세계에 약 16만 건이 발생하는 것으로 예측한다.